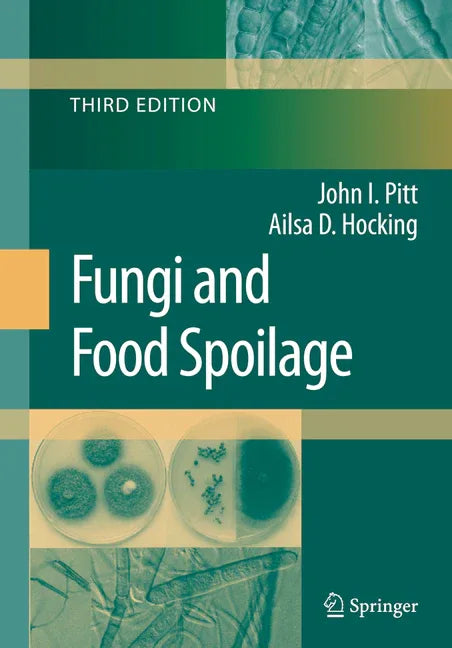
Fungi and Food Spoilage (2009) - stevensbooks

1
/
of
1
Fungi and Food Spoilage (2009)
Fungi and Food Spoilage (2009)
Regular price
$249.99 USD
Regular price
$254.99 USD
Sale price
$249.99 USD
Unit price
/
per
Shipping calculated at checkout.
Out of stock
Couldn't load pickup availability
In contrast to the second edition, the third edition of ''Fungi and Food Spoilage'' is evolutionary rather than revolutionary. The second edition was intended to cover almost all of the species likely to be encountered in mainstream food supplies, and only a few additional species have been included in this new edition. The third edition represents primarily an updating - of taxonomy, physiology, mycotoxin production and ecology. Changes in taxonomy reflect the impact that molecular methods have had on our understanding of classification but, it must be said, have not radically altered the overall picture. The improvements in the understanding of the physiology of food spoilage fungi have been relatively small, reflecting perhaps the lack of emphasis on physiology in modern mic- biological science. Much remains to be understood about the specificity of particular fungi for particular substrates, of the influence of water activity on the growth of many of the species treated, and even on such basic parameters as cardinal temperatures for growth and the influence of pH and preservatives. Since 1997, a great deal has been learnt about the specificity of mycotoxin production and in which commodities and products-specific mycotoxins are likely to occur. Changes in our understanding of the ecology of the included species are also in most cases evolutionary. A great number of papers have been published on the ecology of foodborne fungi in the past few years, but with few exceptions the basic ecology of the included species remains.
Product Information
Product Information
In contrast to the second edition, the third edition of ''Fungi and Food Spoilage'' is evolutionary rather than revolutionary. The second edition was intended to cover almost all of the species likely to be encountered in mainstream food supplies, and only a few additional species have been included in this new edition. The third edition represents primarily an updating - of taxonomy, physiology, mycotoxin production and ecology. Changes in taxonomy reflect the impact that molecular methods have had on our understanding of classification but, it must be said, have not radically altered the overall picture. The improvements in the understanding of the physiology of food spoilage fungi have been relatively small, reflecting perhaps the lack of emphasis on physiology in modern mic- biological science. Much remains to be understood about the specificity of particular fungi for particular substrates, of the influence of water activity on the growth of many of the species treated, and even on such basic parameters as cardinal temperatures for growth and the influence of pH and preservatives. Since 1997, a great deal has been learnt about the specificity of mycotoxin production and in which commodities and products-specific mycotoxins are likely to occur. Changes in our understanding of the ecology of the included species are also in most cases evolutionary. A great number of papers have been published on the ecology of foodborne fungi in the past few years, but with few exceptions the basic ecology of the included species remains.
Share